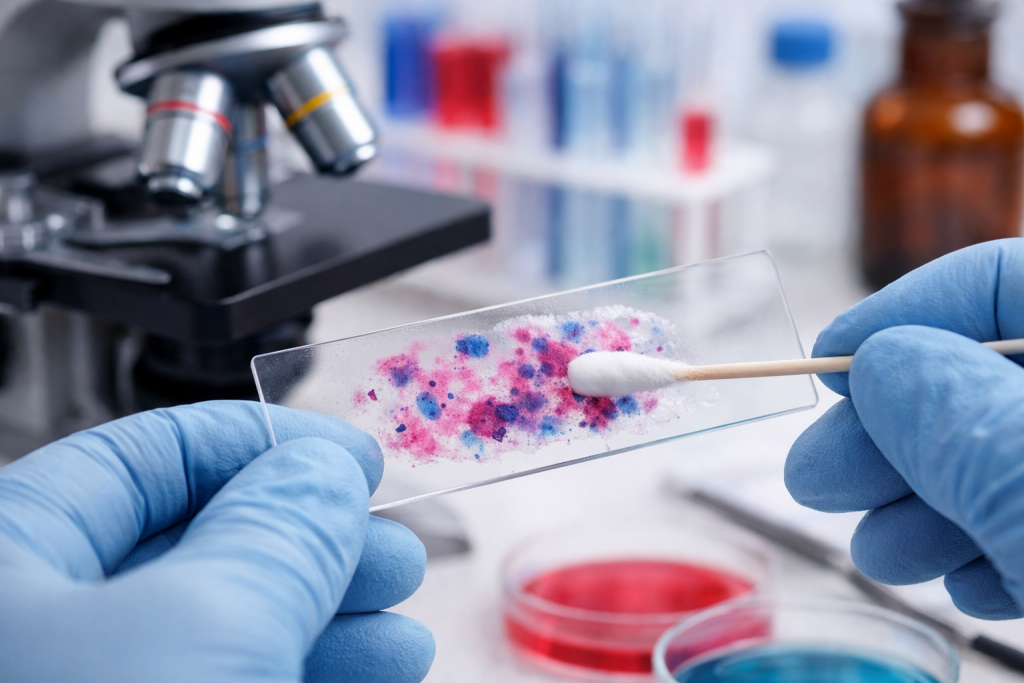
мазок на флору.png

Интимные инфекции могут проявляться зудом, жжением, необычными выделениями и неприятным запахом, но причины таких симптомов бывают разными.
Почему тема интимных инфекций важна
Выделения из влагалища сами по себе не являются признаком болезни. Их количество, консистенция и оттенок могут меняться в разные периоды жизни, во время беременности, на фоне менструального цикла и в период менопаузы. У части женщин изменения появляются после стресса, смены средств гигиены или приема лекарств. Поэтому не каждое отклонение означает инфекцию. Но если к изменениям присоединяются зуд, жжение, неприятный запах или боль, нужна консультация врача.
Влагалище в норме не является стерильной средой. В нем живут разные микроорганизмы, а важную защитную роль играют лактобактерии, которые помогают поддерживать кислую среду. Когда баланс микрофлоры нарушается, создаются условия для роста бактерий, грибков или простейших. Именно тогда появляются симптомы воспаления и дискомфорта. Такая ситуация может возникнуть у женщин разного возраста.
Интимные инфекции относятся к числу самых частых причин обращения к гинекологу. Они могут быть связаны не только с заражением извне, но и с внутренним нарушением баланса микрофлоры. Одни состояния развиваются после антибиотиков или гормональных изменений, другие передаются половым путем. У некоторых пациенток симптомы выражены ярко, а у других долго остаются едва заметными. Поэтому ориентироваться только на собственные ощущения бывает недостаточно.
Для сайта клиники важно говорить об этой теме спокойно и без запугивания. Большинство таких состояний хорошо поддаются лечению, если диагноз поставлен вовремя. Гораздо опаснее затягивать с визитом и пытаться лечиться наугад. Самодиагностика по цвету выделений или советам из интернета часто приводит к ошибкам. Намного надежнее пройти осмотр и получить лечение, которое соответствует реальной причине симптомов.
Что считается нормой, а что поводом для обращения
Физиологические выделения обычно не вызывают зуда, боли и выраженного раздражения. Они могут быть прозрачными или светлыми, без резкого неприятного запаха. Их объем меняется в течение цикла, что само по себе не считается патологией. Отдельное значение имеют возраст, беременность и гормональный фон. Именно поэтому норму всегда оценивают с учетом конкретной ситуации.
Насторожить должны не только цвет и густота выделений, но и сопутствующие симптомы. Если появляются жжение, зуд, болезненность при мочеиспускании или во время полового контакта, это уже не вариант нормы. Важным признаком становится и резкий запах, особенно если он возник внезапно. Иногда женщины замечают покраснение, отечность или чувство постоянного раздражения. Все эти жалобы требуют внимания и обследования.
Особенно важно не откладывать визит, если симптомы появились после незащищенного секса или смены полового партнера. В этой ситуации врач оценивает не только вероятность бактериального вагиноза или кандидоза, но и инфекции, передающиеся половым путем. Некоторые из них могут протекать малосимптомно и давать осложнения позже. По этой причине даже незначительные жалобы после рискованного контакта требуют проверки. Чем раньше проведена диагностика, тем проще и точнее лечение.
Обратиться к врачу стоит и тогда, когда похожие эпизоды повторяются несколько раз в год. Рецидивы могут быть связаны с хроническими факторами риска, ошибками в терапии или сопутствующими заболеваниями. Иногда под маской “обычной молочницы” скрывается совсем другое состояние. Без осмотра и анализов это определить трудно. Повторяющиеся симптомы всегда требуют более внимательной оценки причины.
Основные виды интимных инфекций
Под общим названием “интимные инфекции” чаще всего подразумевают несколько разных состояний. Наиболее распространены бактериальный вагиноз, вульвовагинальный кандидоз и трихомониаз. Кроме них, похожие жалобы могут давать некоторые инфекции, передающиеся половым путем, а также неинфекционные причины, например снижение уровня эстрогенов. Симптомы у этих состояний могут пересекаться. Именно поэтому точный диагноз ставится не по одному признаку, а по совокупности данных.
Бактериальный вагиноз развивается тогда, когда нарушается баланс нормальной микрофлоры и снижается доля защитных лактобактерий. Для него характерны жидкие выделения и неприятный запах, который многие описывают как рыбный. При этом выраженное воспаление бывает не всегда. Состояние не сводится к “грязи” или плохой гигиене, как иногда ошибочно думают. Это именно нарушение микробного баланса, требующее правильной оценки.
Кандидоз, который в быту часто называют молочницей, связан с избыточным ростом дрожжеподобных грибков. Чаще всего он проявляется зудом, жжением и густыми белыми выделениями. У некоторых пациенток симптомы усиливаются во время полового контакта или мочеиспускания. При этом кандидоз не всегда относится к инфекциям, передающимся половым путем. Он может возникать и без сексуальных контактов.
Трихомониаз относится к инфекциям, передающимся половым путем. Для него характерны выделения, раздражение, дискомфорт и иногда боль при мочеиспускании. Однако часть людей вообще не замечает симптомов, из-за чего инфекция может сохраняться долго. Именно бессимптомное течение часто становится причиной позднего выявления. Поэтому при подозрении на ИППП обследование необходимо даже при умеренных жалобах.

Почему развивается нарушение микрофлоры
Причины интимных инфекций разнообразны, и не все они связаны с заражением от партнера. Иногда решающим фактором становится изменение внутренней среды влагалища. На микрофлору влияют гормональный фон, прием лекарств, особенности ухода и состояние иммунной системы. Даже временное нарушение баланса может вызвать дискомфорт. Поэтому врачу важно оценивать не только симптомы, но и образ жизни пациентки.
Частым фактором риска становится прием антибиотиков. Эти препараты могут изменить состав нормальной микрофлоры и создать условия для избыточного роста грибков. У части женщин симптомы появляются во время лечения или вскоре после него. Похожее влияние могут оказывать и некоторые гормональные изменения. Именно поэтому повторяющиеся эпизоды требуют обсуждения с врачом.
К факторам, которые действительно могут повышать риск проблемы, относятся:
-
незащищенные половые контакты;
-
смена полового партнера;
-
частые спринцевания и агрессивные средства для интимной гигиены;
-
ношение тесного, плохо пропускающего воздух белья;
-
самолечение без подтвержденного диагноза.
Этот список не означает, что инфекция возникает только по одной причине. Обычно речь идет о сочетании нескольких обстоятельств. Например, после антибиотиков риск повышается еще сильнее, если одновременно используются раздражающие средства ухода. У некоторых пациенток свою роль играют сахарный диабет, беременность или снижение местной защиты слизистых. Поэтому в беседе с врачом важны даже те детали, которые сначала кажутся незначительными.
Важно понимать и то, что общественные места не считаются основной причиной большинства таких инфекций. Намного чаще решающее значение имеют половые контакты, нарушение микрофлоры и индивидуальные факторы риска. Популярное объяснение “заразилась в бассейне” не всегда подтверждается на практике. Намного полезнее не искать случайную бытовую причину, а пройти диагностику. Это позволяет быстрее выбрать верное лечение и снизить риск повторения симптомов.
Как меняются симптомы при разных состояниях
Симптомы интимных инфекций могут быть похожими, но некоторые особенности все же помогают врачу предположить причину. При бактериальном вагинозе выделения нередко становятся более жидкими, а запах — более выраженным. При кандидозе на первый план часто выходят зуд, жжение и творожистые выделения. При трихомониазе возможны желтовато-зеленые выделения и раздражение слизистой. Но даже типичная картина не заменяет обследование.
Часто пациентки обращают внимание только на цвет выделений. На практике врачу важны и другие признаки: запах, объем, наличие боли, связь симптомов с циклом и сексуальной активностью. Иногда решающую роль играет не внешний вид секрета, а жалобы на дискомфорт при мочеиспускании или во время близости. Также учитывается, появились ли симптомы впервые или повторяются регулярно. Такая детализация помогает не ошибиться в диагнозе.
Наиболее частые симптомы, при которых стоит записаться на прием:
-
необычные по цвету или консистенции выделения;
-
зуд, жжение или раздражение в интимной зоне;
-
неприятный запах;
-
боль при мочеиспускании или половом контакте;
-
покраснение, отечность, чувство дискомфорта.
Иногда симптомы бывают стертыми. Например, при трихомониазе человек может долго не замечать явных проявлений, но оставаться источником инфекции. При бактериальном вагинозе иногда преобладает только запах без выраженного зуда. При кандидозе жалобы могут усиливаться волнообразно и временно уменьшаться без лечения. Именно поэтому исчезновение симптомов на несколько дней не означает полного выздоровления.
Когда симптомы требуют срочного внимания
Не каждая интимная инфекция требует неотложной помощи, но есть ситуации, когда медлить не стоит. Особенно важно быстро обратиться к врачу, если помимо выделений появились сильная боль, температура или кровянистые выделения вне менструации. Такие симптомы могут указывать не только на вагинит, но и на другие состояния, требующие очной оценки. Врач должен исключить инфекции, поднимающиеся выше, а также сопутствующие заболевания органов малого таза. Самостоятельно отличить одно от другого сложно.
Беременность — отдельная причина не заниматься самолечением. В этот период изменения выделений встречаются часто, но любое подозрение на инфекцию требует аккуратной диагностики. Не все препараты одинаково подходят беременным, а некоторые схемы лечения подбираются только врачом. Кроме того, часть инфекций во время беременности требует особенно внимательного наблюдения. Поэтому при появлении симптомов важно записаться на прием как можно раньше.
Поводом для срочного обращения также становятся симптомы после незащищенного контакта с новым партнером. Даже если жалобы умеренные, врач может рекомендовать обследование на инфекции, передающиеся половым путем. Это важно не только для лечения, но и для защиты репродуктивного здоровья в будущем. Некоторые ИППП могут протекать скрыто и обнаруживаться только при лабораторной диагностике. Чем раньше проведено обследование, тем лучше прогноз.
Отдельного внимания заслуживают повторные эпизоды, когда симптомы возвращаются после краткого улучшения. Это может означать неверный диагноз, неполное лечение или наличие дополнительного фактора риска. Иногда проблема связана сразу с несколькими состояниями, которые развиваются одновременно. В таких случаях одного “универсального” средства обычно недостаточно. Нужен план лечения, основанный на результатах осмотра и анализов.
Как врач ставит диагноз
Диагностика начинается с обычной беседы и уточнения жалоб. Врач спрашивает, когда появились симптомы, были ли похожие эпизоды раньше, какие препараты принимались недавно и есть ли связь с половыми контактами. Также учитываются беременность, менопауза, хронические заболевания и особенности цикла. Эти сведения важны не меньше, чем лабораторный результат. На их основе выбирается объем обследования.
Во время приема гинеколог оценивает состояние слизистых, характер выделений и признаки воспаления. При необходимости выполняются тесты, позволяющие уточнить причину симптомов. В клинической практике могут использоваться измерение pH, микроскопия, тесты на ИППП и другие методы. Набор исследований зависит от предполагаемого диагноза. Именно поэтому стандартного анализа “на все сразу” не существует.
На приеме врач обычно уточняет такие моменты:
-
когда начались симптомы и как они менялись;
-
есть ли зуд, запах, боль или жжение;
-
были ли антибиотики, новые средства гигиены или смена партнера;
-
возможна ли беременность;
-
были ли ранее рецидивы и чем они лечились.
Заявка принята
Спасибо! Ваше сообщение отправлено!
Самодиагностика по внешнему виду выделений часто подводит. Белые выделения не всегда означают кандидоз, а неприятный запах не всегда связан только с бактериальным вагинозом. Кроме того, некоторые ИППП и неинфекционные состояния могут имитировать похожую картину. Именно поэтому покупка случайного препарата “от всего” нередко затягивает проблему. Точная диагностика экономит время и снижает риск повторного воспаления.
Принципы лечения интимных инфекций
Лечение всегда зависит от причины. При кандидозе применяются противогрибковые средства, при бактериальном вагинозе и некоторых ИППП — антибактериальные препараты или другие схемы, которые подбирает врач. Универсального лекарства, подходящего для всех случаев, не существует. Даже одинаковые на первый взгляд симптомы могут требовать разного подхода. Поэтому правильное лечение начинается не с покупки препарата, а с диагностики.
Часть препаратов используется местно, часть назначается внутрь. Выбор зависит от диагноза, тяжести симптомов, беременности, сопутствующих заболеваний и частоты рецидивов. Важно пройти курс полностью, даже если стало лучше уже через несколько дней. Преждевременная отмена повышает риск возврата симптомов. Также не стоит самостоятельно менять дозировку или комбинировать несколько средств без рекомендации врача.
Во время лечения обычно рекомендуют:
-
отказаться от половых контактов до окончания терапии или следовать указаниям врача;
-
не использовать спринцевания и раздражающие средства;
-
носить удобное белье из дышащих тканей;
-
соблюдать схему приема препаратов без пропусков;
-
обратиться на повторный прием, если симптомы не уменьшаются.
При некоторых инфекциях вопрос лечения полового партнера тоже имеет значение. Например, при трихомониазе это часть профилактики повторного заражения. А вот при бактериальном вагинозе лечение партнера-мужчины обычно не требуется. Именно поэтому советы “лечиться обоим всегда” или “партнер не имеет значения никогда” одинаково упрощают реальную ситуацию. Решение должно опираться на конкретный диагноз.
Что можно купить без рецепта и где нужна осторожность
Безрецептурные средства действительно существуют, но использовать их стоит осмотрительно. Например, клотримазол может применяться при кандидозе, если его причина действительно подтверждена или очень вероятна. Однако похожие симптомы бывают и при других состояниях, где такой препарат не поможет. В результате женщина теряет время, а воспаление продолжается. Именно поэтому даже безрецептурные лекарства желательно обсуждать с врачом.
Иногда пациентки дополнительно используют пробиотики. Их роль может обсуждаться как поддерживающая мера, но они не заменяют основное лечение, если уже есть выраженная инфекция. Особенно это важно при бактериальном вагинозе и трихомониазе, когда необходима конкретная терапия. Ставка только на “восстановление флоры” без лечения причины обычно не решает проблему. Поэтому пробиотики стоит рассматривать как дополнительный, а не основной инструмент.
С осторожностью стоит относиться и к средствам с раздражающим действием. Любые кислые, щелочные или агрессивные растворы могут усилить дискомфорт и ухудшить состояние слизистой. Даже если подобные способы широко обсуждаются в быту, это не делает их безопасными. Интимная зона особенно чувствительна к самовольным экспериментам. Поэтому лучше выбирать методы с понятной эффективностью и прогнозируемым действием.
Если симптомы повторяются, усиливаются или не проходят после безрецептурного средства, необходимо очное обследование. Повторение одного и того же препарата без диагноза — частая причина затяжного течения. Кроме того, за “молочницей” могут скрываться бактериальный вагиноз, трихомониаз или смешанная инфекция. В такой ситуации лечение нужно менять, а не просто продлевать прежнюю схему. Чем раньше пациентка обращается в клинику, тем быстрее удается восстановить комфорт.

Домашние методы: что действительно помогает, а что мешает
При появлении неприятных симптомов многим хочется начать с домашних способов. Это понятная реакция, особенно если визит к врачу откладывается. Но важно разделять меры, которые снижают раздражение, и методы, которые могут навредить. Домашний уход не должен подменять диагностику и лечение. Особенно это важно при подозрении на инфекцию, передающуюся половым путем.
Полезнее всего в период дискомфорта уменьшить все, что дополнительно раздражает слизистую. Лучше отказаться от ароматизированных гелей, ежедневных прокладок с отдушками и тесного синтетического белья. Также стоит избегать спринцеваний и частого “интенсивного” подмывания. Чрезмерная гигиена может нарушить естественный баланс не меньше, чем ее недостаток. Простые щадящие меры часто оказываются разумнее популярных народных советов.
В домашних условиях допустимы только щадящие меры поддержки:
-
мягкая интимная гигиена без агрессивных средств;
-
сухое и удобное белье из дышащих тканей;
-
временный отказ от половых контактов при выраженных симптомах;
-
соблюдение схемы лечения, назначенной врачом;
-
достаточное питье и общее внимание к самочувствию.
Не рекомендуется самостоятельно применять уксус, соду, эфирные масла и другие раздражающие вещества на слизистые. Несмотря на популярность таких советов, они могут усилить жжение, вызвать дополнительное раздражение и смазать клиническую картину. Это особенно нежелательно перед обследованием у гинеколога. Если состояние ухудшается, не нужно продолжать эксперименты дома. Правильнее обратиться в клинику и получить безопасную схему помощи.
Интимные инфекции и половая жизнь
Во время активных симптомов половые контакты нередко усиливают дискомфорт. Жжение, боль и раздражение могут становиться заметнее после близости, а восстановление слизистой — затягиваться. Поэтому на период лечения врач часто рекомендует воздержание или иные ограничения. Это касается не только удобства пациентки, но и профилактики повторного заражения. Особенно важно соблюдать рекомендации при подтвержденных ИППП.
Не все интимные инфекции передаются половым путем. Например, кандидоз может развиваться и без сексуальных контактов, а бактериальный вагиноз связан прежде всего с нарушением микробного баланса. Но сексуальная активность может влиять на риск появления или повторения симптомов. Кроме того, при трихомониазе половой путь передачи играет ключевую роль. Поэтому обсуждение сексуальной жизни с врачом — это не формальность, а часть диагностики.
Иногда пациентки стесняются говорить о таких деталях на приеме. На практике именно эти сведения помогают врачу понять, нужен ли поиск ИППП, требуется ли лечение партнера и как снизить риск рецидива. Для врача это обычная часть медицинской беседы, а не повод для оценки или осуждения. Чем точнее информация, тем точнее рекомендации. Открытый разговор делает лечение эффективнее. Это особенно важно при повторяющихся воспалениях.
После завершения лечения полезно ориентироваться не только на исчезновение симптомов, но и на рекомендации врача по дальнейшему поведению. В некоторых случаях нужен контроль, в других — достаточно наблюдения за самочувствием. При повторном появлении жалоб не следует сразу возвращаться к старой схеме самостоятельно. Причина нового эпизода может отличаться от предыдущей. Гораздо надежнее снова пройти оценку и не лечить “по памяти”.
Как снизить риск рецидивов
Профилактика интимных инфекций строится не на одном запрете, а на разумном уходе за собой. Полностью исключить риск невозможно, но уменьшить вероятность повторных эпизодов реально. Для этого важны деликатная гигиена, внимательное отношение к симптомам и своевременное обращение за помощью. Большое значение имеют и общие факторы здоровья. Чем меньше раздражающих воздействий и случайного самолечения, тем стабильнее местный баланс.
В основе профилактики лежит бережное отношение к интимной зоне. Не стоит использовать агрессивные средства, ароматизированные продукты и практиковать спринцевания без медицинских показаний. Лучше выбирать удобное белье и не оставлять без внимания повторяющийся дискомфорт. При смене партнера особенно важны меры защиты и настороженность к новым симптомам. Простые привычки в этом вопросе действительно работают.
Снизить риск повторения помогают такие меры:
-
использовать барьерную защиту при риске ИППП;
-
не заниматься самолечением при повторных симптомах;
-
обсуждать с врачом эпизоды после антибиотиков;
-
не злоупотреблять средствами интимной гигиены;
-
приходить на прием, если жалобы возвращаются несколько раз в год.
Отдельную роль играет общее состояние организма. Контроль хронических заболеваний, полноценный сон, снижение стресса и внимание к питанию помогают поддерживать нормальную защиту слизистых. Это не заменяет лечение, но создает более благоприятные условия для восстановления. Если эпизоды повторяются часто, врач может предложить дополнительное обследование. Такой подход помогает не только снять симптомы, но и воздействовать на причину рецидивов.

Когда лучше не ждать и записаться в клинику
Многие пациентки откладывают визит, надеясь, что неприятные ощущения пройдут сами. Иногда симптомы действительно временно уменьшаются, но это не всегда означает выздоровление. Затяжное воспаление ухудшает качество жизни, нарушает сон, интимный комфорт и повседневную активность. Кроме того, при ИППП промедление повышает риск дальнейшей передачи инфекции. Поэтому откладывать осмотр невыгодно и с медицинской, и с бытовой точки зрения.
В клинику стоит обратиться при любых нетипичных выделениях, стойком зуде, неприятном запахе и боли. Отдельный повод для визита — симптомы после незащищенного контакта, во время беременности или на фоне повторяющихся эпизодов. На приеме врач сможет отличить инфекцию от других состояний, которые тоже вызывают похожие жалобы. Это особенно важно в период менопаузы, когда симптомы не всегда связаны именно с инфекцией. Чем точнее диагноз, тем спокойнее и понятнее лечение.
Современный подход к лечению интимных инфекций основан на уважительном общении, точной диагностике и индивидуальном подборе терапии. Для пациентки это означает не только устранение симптомов, но и снижение риска повторных эпизодов. Важно, чтобы на приеме можно было без стеснения обсудить жалобы, образ жизни и тревожащие вопросы. Именно такая открытая медицинская коммуникация помогает получить лучший результат. Забота о здоровье начинается с готовности обратиться за профессиональной помощью.
Если симптомы уже появились, лучше не подбирать лечение самостоятельно по описанию из интернета или чужому опыту. Даже похожие жалобы могут иметь разные причины и требовать разных препаратов. Врачебная оценка помогает избежать ошибок, сократить срок лечения и сохранить комфорт. А при повторных инфекциях она дает возможность разобраться, почему проблема возвращается. Своевременная консультация — это самый надежный путь к восстановлению интимного здоровья.
Почему выбирают нас?
Персональные предложения для вас
Услуги нашей клиники
Статья проверена врачами Семейной клиники «Жизнь-Опора»
Адрес клиники
Сб – Вс с 9:00 до 19:00
Сб – Вс с 9:00 до 19:00
- Комментарии

